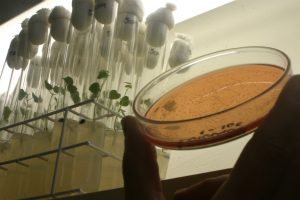

SLC Agrícola lança segunda edição do programa AgroExponencial
A SLC Agrícola acredita que inovar e adotar novas tecnologias é decisivo para a sustentabilidade do negócio e para a definição do futuro do agro. Por

A SLC Agrícola acredita que inovar e adotar novas tecnologias é decisivo para a sustentabilidade do negócio e para a definição do futuro do agro. Por
A Interação representa uma evolução na proteção dos cultivos, ofertando melhor desempenho e eficiência. A agricultura moderna permitiu alimentar o mundo graças a aumentos contínuos

Cálculo da quantidade de sementes de trigo deve considerar peso de mil sementes (PMS). Aplicativo gratuito faz uma estimativa de quantos kg irá precisar para semear sua área de trigo, soja e milho.

Olá, Servir a indústria de movimentação de materiais por mais de 90 anos nos ensinou muitas coisas, mas uma lição se mostrou mais importante do

Olá, Servir a indústria de movimentação de materiais por mais de 90 anos nos ensinou muitas coisas, mas uma lição se mostrou mais importante do

Doze equipamentos de grandes dimensões foram fornecidos a duas unidades hospitalares construídas recentemente em Wuhan, na China Entre janeiro e fevereiro deste ano, o governo

Prezado cliente, Nós da organização da Concrete Show South America 2020, comunicamos que estamos acompanhando diariamente a progressão do COVID-19 indicada pelos órgãos de vigilância sanitária

Medidas de prevenção da Palazzani Industrie S.p.A., trabalho inteligente e mais atividades para proteger a saúde dos funcionários durante emergências. Durante a difícil situação relacionada

A versatilidade da nova caçamba processadora MB-HDS permite tratar uma ampla gama de materiais diretamente no canteiro, sem custos adicionais. Se lhe dissessem que, no

Alinhada com as ações de combate ao Covid-19, a empresa mudou a data do Treinamento em Tecnologias Metso (TTM) para a semana de 24 a 28
Deixe seu Email para acompanhar as novidades
